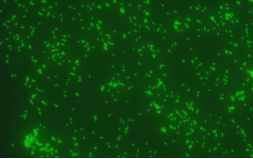
image.png

Gardnerella vaginalis monoclonal antibody
Source
Monoclonal Anti- Gardnerella vaginalis Antibody,Rabbit IgG is a Rabbit monoclonal antibody expressed from CHO
Isotype
Rabbit IgG
Conjugate
Unconjugated
Antibody Type
Recombinant Monoclonal
Reactivity
Bacteria
Immunogen
Whole cells of Gardnerella vaginalis
Specificity
This product is a specific antibody specifically reacts with Gardnerella vaginalis.
Purity
>95% as determined by SDS-PAGE.
Purification
Affinity purification Protein G
Formulation
Supplied as a 0.22 μm filtered solution of PBS, pH7.4
Application
Application Recommended Usage
ELISA 1~10μg/mL
Storage
This antibody can be stored at 2℃-8℃ for one month without detectable loss of activity. Antibody products are stable for twelve months from date of receipt when stored at -20℃ to -80℃. Preservative-Free. Avoid repeated freeze-thaw cycles.
Cross Verification
Tested with no cross-reactivity with Candida albicans.
SDS-PAGE
M R

Gardnerella vaginalis monoclonal antibody on SDS-PAGE under reducing (R) condition.
The gel was stained with Coomassie Blue. The purity of the protein is greater than 90%
Bioactivity-ELISA

Immobilized native Gardnerella vaginalis. Binding activity of Gardnerella vaginalis antibodies.
In immunofluorescence applications
Background
Bacterial vaginosis is a disease of the vaginal microbiota that seriously affects women's health, especially causing adverse pregnancy outcomes during pregnancy and endangering the health of both the mother and the fetus. Gardnerella vaginalis is one of the important pathogenic bacteria of bacterial vaginosis. Gardnerella vaginalis can adhere to vaginal epithelial cells, promote the formation of multi-microbial biofilms, and promote the release of various virulence factors such as pro-inflammatory cytokines, sialidase and vaginal cytolytic toxin, thereby affecting the immune response of the body; it can also change the expression of related genes by releasing certain signals, and interact with certain microorganisms in the vaginal microecology to alter the composition of the vaginal microbiota, leading to various adverse outcomes.